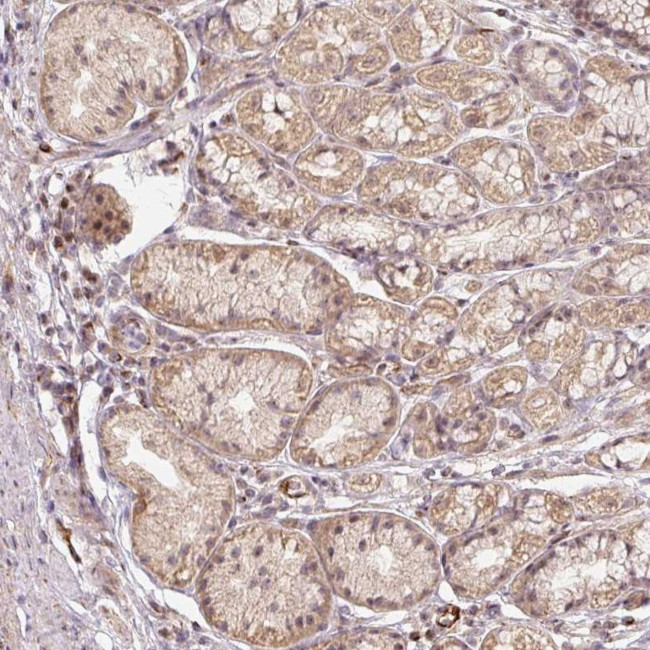
MMACHC Antibody in Immunohistochemistry (IHC)

Search
Invitrogen
MMACHC Polyclonal Antibody
{{$productOrderCtrl.translations['antibody.pdp.commerceCard.promotion.promotions']}}
{{$productOrderCtrl.translations['antibody.pdp.commerceCard.promotion.viewpromo']}}
{{$productOrderCtrl.translations['antibody.pdp.commerceCard.promotion.promocode']}}: {{promo.promoCode}} {{promo.promoTitle}} {{promo.promoDescription}}. {{$productOrderCtrl.translations['antibody.pdp.commerceCard.promotion.learnmore']}}
产品信息
PA5-55596
种属反应
宿主/亚型
分类
类型
抗原
偶联物
形式
浓度
规格
纯化类型
保存液
内含物
保存条件
运输条件
RRID
产品详细信息
Immunogen sequence: NFHWRDWTYR DAVTPQERYS EEQKAYFSTP PAQRLALLGL AQPSEKPSSP SPDLPFTTPA PKKPGNPSRA RSWLSPRVSP PAS
Highest antigen sequence identity to the following orthologs: Mouse - 77%, Rat - 74%.
靶标信息
The exact function of the MMACHC protein is not known, however, its C-terminal region shows similarity to TonB, a bacterial protein involved in energy transduction for cobalamin (vitamin B12) uptake. Hence, it is postulated that this protein may have a role in the binding and intracellular trafficking of cobalamin. Mutations in this gene are associated with methylmalonic aciduria and homocystinuria type cblC.
仅用于科研。不用于诊断过程。未经明确授权不得转售。
篇参考文献 (0)
生物信息学
蛋白别名: Alkylcobalamin:glutathione S-alkyltransferase; CblC; Cyanocobalamin reductase (cyanide-eliminating); Cyanocobalamin reductase / alkylcobalamin dealkylase; methylmalonic aciduria (cobalamin deficiency) cblC type, with homocystinuria; Methylmalonic aciduria and homocystinuria type C protein; MMACHC; RP11-291L19.3
基因别名: cblC; MMACHC
UniProt ID: (Human) Q9Y4U1
Entrez Gene ID: (Human) 25974